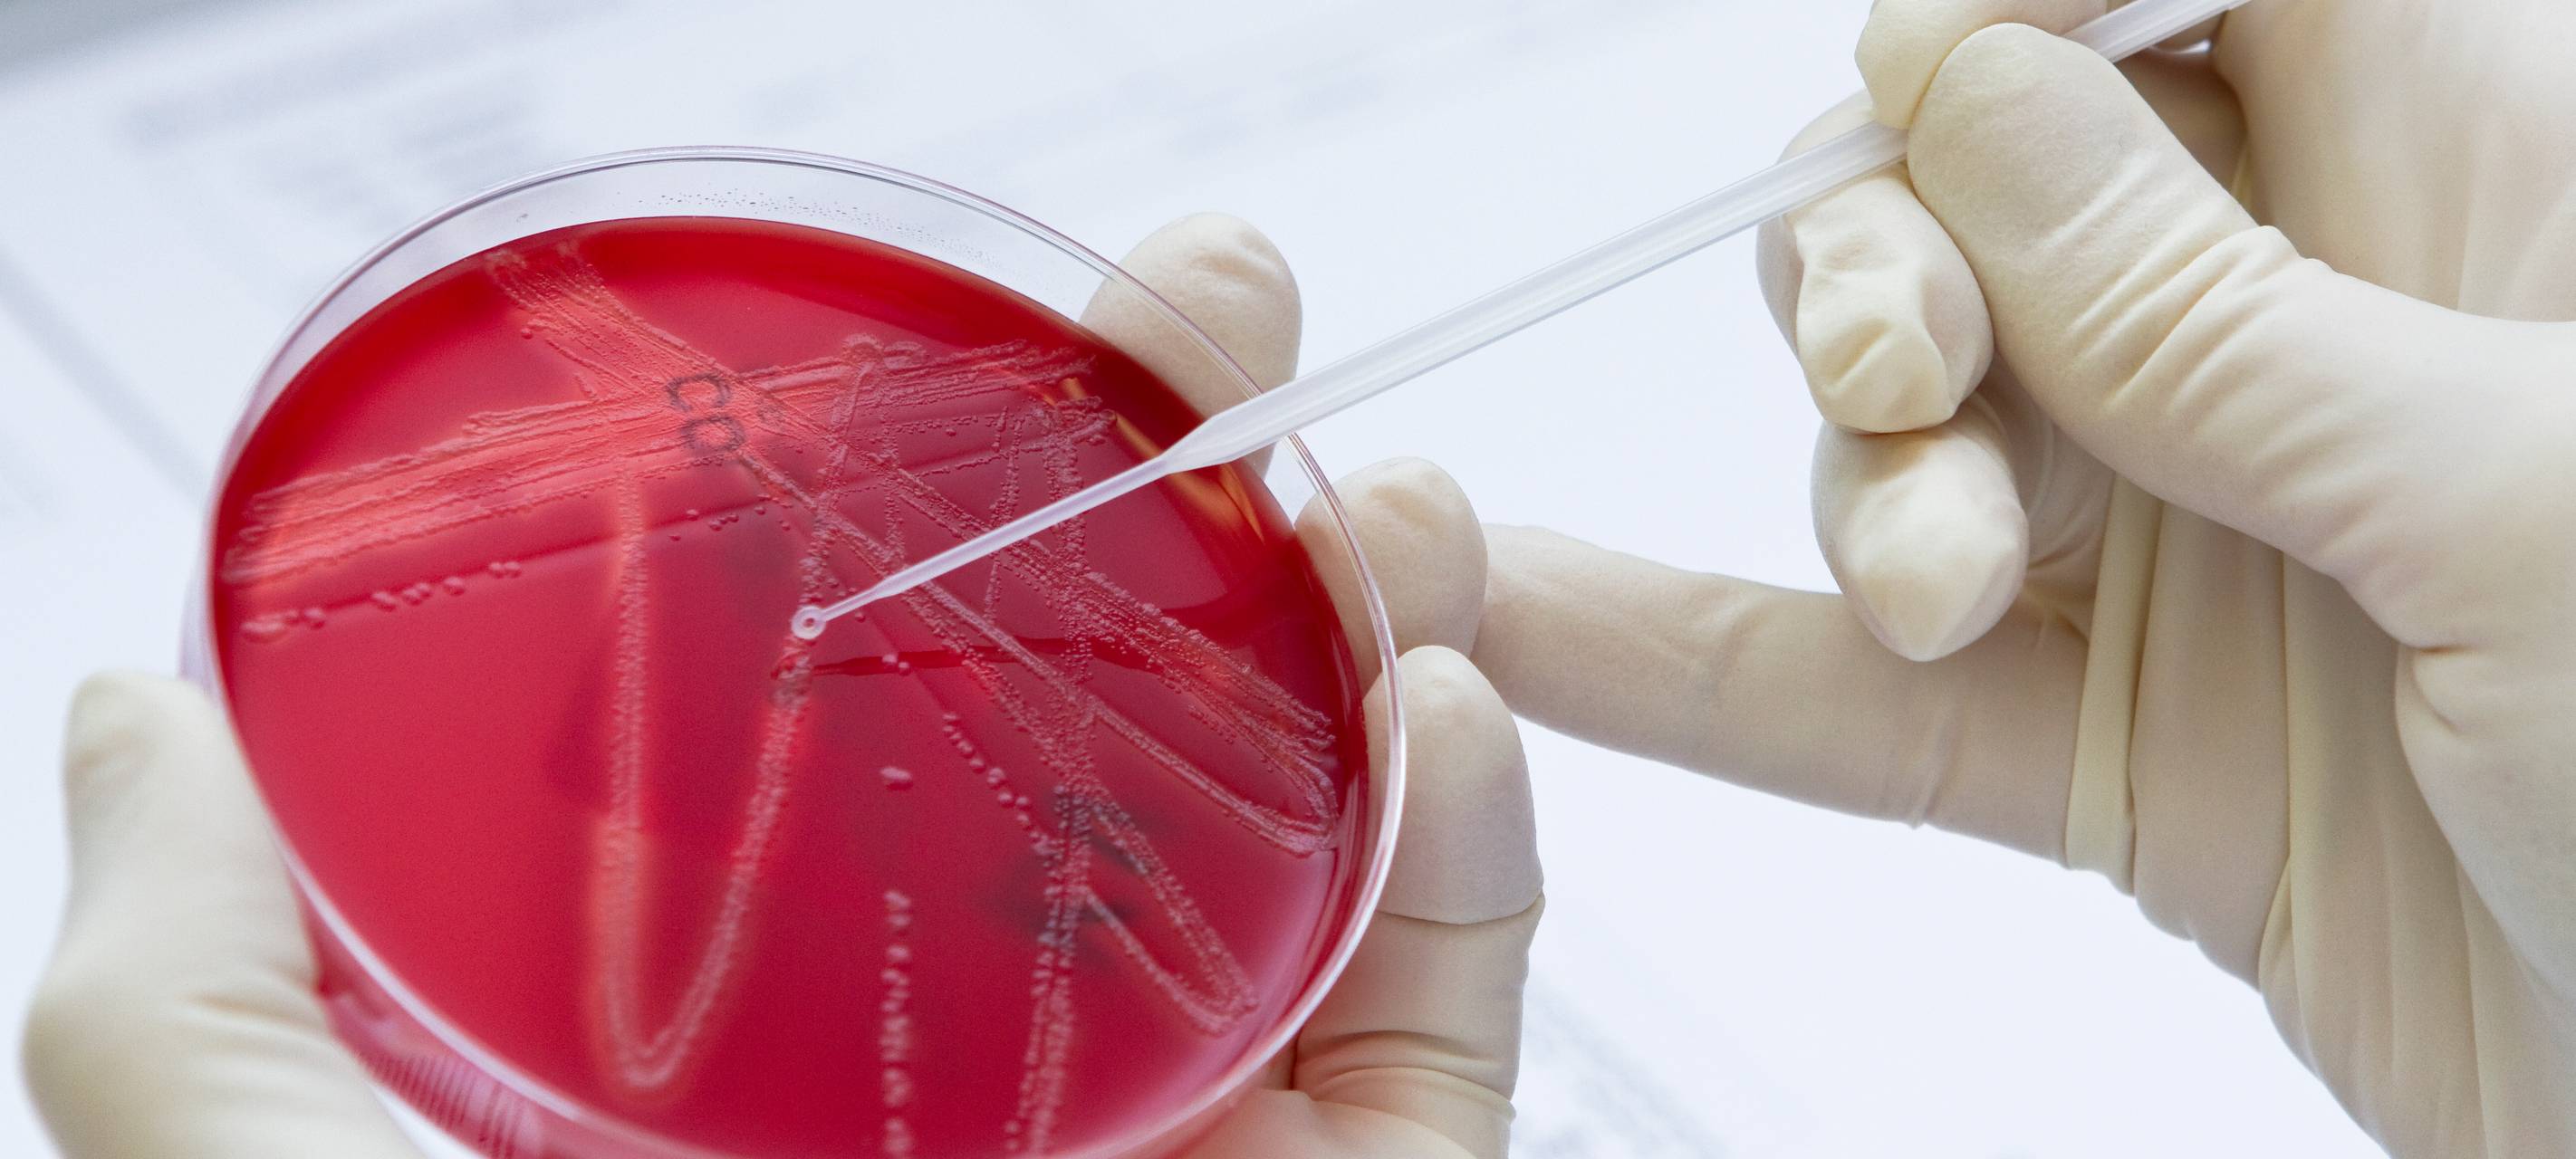
Petrischale im Labor

Corona in Lüdenscheid: Labore mit PCR-Testauswertungen am Limit
Viele Labore arbeiten am Limit weil die neuen Quarantäne-Regeln wesentlich mehr PCR-Tests vorsehen. Im Medizinischen Labor Wahl in Lüdenscheid hat sich die Situation seit dieser Woche weiter verschärft, mit 2.600 PRC-Tests allein am Montag hat sich die Zahl noch einmal um 50 Prozent erhöht.
Veröffentlicht: Donnerstag, 20.01.2022 08:52
Dr. Hans Günther Wahl vom Medizinischen Labor Wahl in Lüdenscheid beschreibt, was das für seine Mitarbeiter bedeutet:
Trotz der hohen Auslastung und dem weiterlaufenden Alltagsgeschäft liegen die Testergebnisse in dem Labor in der Regel nach 24 Stunden vor. Die schnellsten Proben bereits nach 7 Stunden. Auch viele Schülerinnen und Schüler bekommen die Überlastung der Labore am eigenen Leib zu spüren: weil die Auswertung der PCR-Tests so lange dauert, können sie teilweise nicht in die Schule kommen.